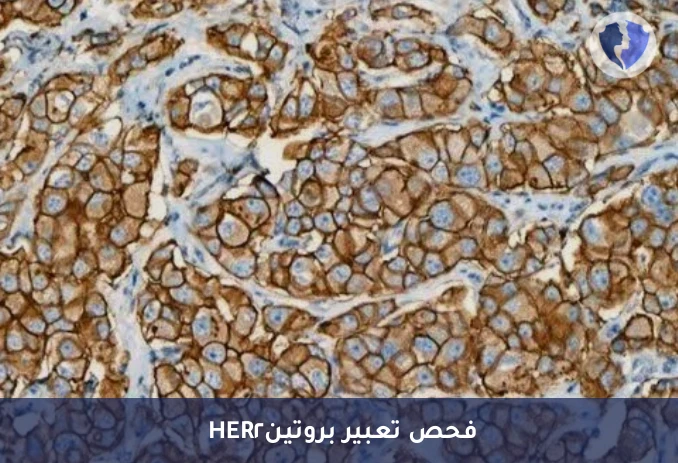
فحص مستقبلات سرطان الثدي والمعدة - فحص مستقبل HER2 الكيميائي النسيجي المناعي (HER2)

تفاصيل الخدمة
فحص مستقبلات سرطان الثدي والمعدة - فحص مستقبل HER2 الكيميائي النسيجي المناعي (HER2)
فحص الكيمياء الهيستولوجية المناعية (IHC) لمستقبل عامل نمو البشرة البشري 2 (HER2/neu) يهدف إلى الكشف عن التعبير البروتيني الزائد لـ HER2 على غشاء الخلايا السرطانية في أنسجة الثدي والمعدة. يُعد هذا الفحص خطوة أولية أساسية (يليه فحص التهجين في الموقع - ISH في الحالات الحدية) لتحديد أهلية المرضى للعلاج بالأجسام المضادة الموجهة ضد HER2، وهو معيار عالمي في إدارة سرطاني الثدي والمعدة.